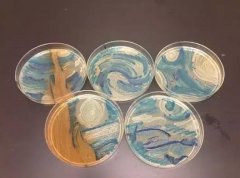
《星夜》再现：科学家利用DNA折纸术复活梵高名作

赏花灯猜灯谜舞布龙 宁波多彩民俗活动欢庆元宵佳节 简介:春节之后,新年第一次月圆,就在正月十五“元宵节”。老宁波的习... 热度:218℃
赏花灯猜灯谜舞布龙 宁波多彩民俗活动欢庆元宵佳节 简介:春节之后,新年第一次月圆,就在正月十五“元宵节”。老宁波的习... 热度:218℃  纸雕与时尚的美丽邂逅!洛杉矶艺术家Jeff Nishinaka的时尚纸艺作品赏,酷到骨子 简介:Jeff Nishinaka是来自来自洛杉矶的纸艺大师,曾经创作了许多精彩绝伦... 热度:218℃
纸雕与时尚的美丽邂逅!洛杉矶艺术家Jeff Nishinaka的时尚纸艺作品赏,酷到骨子 简介:Jeff Nishinaka是来自来自洛杉矶的纸艺大师,曾经创作了许多精彩绝伦... 热度:218℃  浦东时报特供:创意手工DIY受沪上白领追捧 简介:DIY消费需求快速上升,DIY市场也成为具有开发潜力的新兴市场10月... 热度:132℃
浦东时报特供:创意手工DIY受沪上白领追捧 简介:DIY消费需求快速上升,DIY市场也成为具有开发潜力的新兴市场10月... 热度:132℃ 《星夜》再现:科学家利用DNA折纸术复活梵高名作 简介:梵高的《星夜》似乎格外受科学家们青睐。之前就曾有科学家利用细... 热度:104℃
《星夜》再现:科学家利用DNA折纸术复活梵高名作 简介:梵高的《星夜》似乎格外受科学家们青睐。之前就曾有科学家利用细... 热度:104℃  手工折纸草莓的折法详细步骤图解教程 简介:手工折纸草莓的折法详细步骤图解教程,对边谷折,对角线山折,打... 热度:437℃
手工折纸草莓的折法详细步骤图解教程 简介:手工折纸草莓的折法详细步骤图解教程,对边谷折,对角线山折,打... 热度:437℃  叹为观“纸”:广西90后小伙折纸作品(组图) 简介:9月6日,秦坤在用纸折“猫头鹰”作品。广西桂林市90后小伙秦坤,... 热度:162℃
叹为观“纸”:广西90后小伙折纸作品(组图) 简介:9月6日,秦坤在用纸折“猫头鹰”作品。广西桂林市90后小伙秦坤,... 热度:162℃  教宝宝折纸也要讲究方法 简介:豪豪的妈妈非常注重对宝宝的教育,豪豪也因为妈妈的教育得到了良... 热度:157℃
教宝宝折纸也要讲究方法 简介:豪豪的妈妈非常注重对宝宝的教育,豪豪也因为妈妈的教育得到了良... 热度:157℃  爱马仕多哈与折纸设计师刘通联手推出艺术橱窗 简介:近日,爱马仕(Hermès)邀请到中国折纸艺术家、设计师刘通(Tong... 热度:140℃
爱马仕多哈与折纸设计师刘通联手推出艺术橱窗 简介:近日,爱马仕(Hermès)邀请到中国折纸艺术家、设计师刘通(Tong... 热度:140℃  首阳山旅游度假区贵和幼儿园举行折纸大比拼活动 简介:昌乐传媒网3月16日讯(通讯员 郑雪)首阳山旅游度假区贵和幼儿园大班... 热度:89℃
首阳山旅游度假区贵和幼儿园举行折纸大比拼活动 简介:昌乐传媒网3月16日讯(通讯员 郑雪)首阳山旅游度假区贵和幼儿园大班... 热度:89℃  小个子张韶涵穿上折纸裙,挥舞“隐形的翅膀”重回荧屏! 简介:受韩红邀约,好久不见的张韶涵前段时间参加了节目《我想和你唱》... 热度:99℃
小个子张韶涵穿上折纸裙,挥舞“隐形的翅膀”重回荧屏! 简介:受韩红邀约,好久不见的张韶涵前段时间参加了节目《我想和你唱》... 热度:99℃  日本折纸艺术家小林一夫在京演讲促进中日民间交流 简介:2月28日,国际折纸协会理事长、日本东京御茶水折纸会馆馆长小林一... 热度:295℃
日本折纸艺术家小林一夫在京演讲促进中日民间交流 简介:2月28日,国际折纸协会理事长、日本东京御茶水折纸会馆馆长小林一... 热度:295℃  儿童实用折纸大全 简介:本书收集了具有代表性的折纸作品百余例,配有详细步骤,简单易学... 热度:175℃
儿童实用折纸大全 简介:本书收集了具有代表性的折纸作品百余例,配有详细步骤,简单易学... 热度:175℃ ![儿童折纸大全图[整理版]](https://www.fphs5.com/chuangyi/upimg/allimg/170215/1555353P0_lit.gif) 儿童折纸大全图[整理版] 简介:儿童折纸大全图[整理版],儿童折纸大全,儿童折纸大全 图解,儿童手工... 热度:132℃
儿童折纸大全图[整理版] 简介:儿童折纸大全图[整理版],儿童折纸大全,儿童折纸大全 图解,儿童手工... 热度:132℃  从国家非遗广灵剪纸看“窗花”变迁 简介:鸡年来临,金鸡富贵、双鸡送福等一个个寓意祝福的“金鸡”图案,... 热度:69℃
从国家非遗广灵剪纸看“窗花”变迁 简介:鸡年来临,金鸡富贵、双鸡送福等一个个寓意祝福的“金鸡”图案,... 热度:69℃ 
